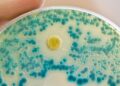
warnung-der-who:-immer-mehr-antibiotika-wirken-nicht-mehr

Bundespräsident Steinmeier „Nie waren Demokratie und Freiheit so angegriffen“
Stand: 09.11.2025 22:16 Uhr
Wachsender Rechtsextremismus, Hass und Populismus – Bundespräsident Steinmeier warnt vor der größten Bedrohung der deutschen Demokratie seit der Wiedervereinigung. Es sei an der Zeit sich einzumischen und für die Freiheit einzustehen.
Anlässlich des 9. Novembers hat Bundespräsident Frank-Walter Steinmeier zum Zusammenhalt und zur Verteidigung der Demokratie in Deutschland aufgerufen. „Mein Wunsch an diesem 9. November ist aus tiefstem Herzen: Stehen wir zusammen – für die Selbstbehauptung von Demokratie und Menschlichkeit! Geben wir nicht preis, was uns ausmacht“, sagte Steinmeier bei einer Matinee im Schloss Bellevue in Berlin.
„Der 9. November steht für Licht und Schatten, für die tiefsten Abgründe und die glücklichsten Stunden unserer Geschichte“, so der Bundespräsident. Er erinnerte an drei besondere Ereignisse, die an diesem Datum stattfanden: die Ausrufung der ersten deutschen Republik 1918, die Novemberpogrome im Dritten Reich 1938 und der Mauerfall 1989. Deshalb berühre der 9. November das Selbstverständnis als Deutsche. Es gehe um den „Kern unserer Identität“.
Steinmeier sieht größte Bedrohung für Demokratie seit Wiedervereinigung
Heute sei die deutsche Demokratie bedroht wie nie zuvor. „Nie in der Geschichte unseres wiedervereinten Landes waren Demokratie und Freiheit so angegriffen“, sagte Steinmeier. Diese seien aktuell vor allem bedroht „durch rechtsextreme Kräfte, die unsere Demokratie angreifen und an Zustimmung in der Bevölkerung gewinnen“. Steinmeier appellierte an Politik und Zivilgesellschaft, sich dagegen zu wehren. „Einfach abzuwarten, dass der Sturm vorbeizieht und solange in sichere Deckung zu gehen, das reicht nicht“, sagte der Bundespräsident.
„Die Rechtsextremen locken mit dem süßen Gift der Wut, ‚die da oben‘ sind der vermeintliche Gegner“, sagte Steinmeier weiter. Sie lockten „mit dem Versprechen autoritärer Führung“ und damit, dass Deutschland „wieder groß sein“ solle. Dem hätten Demokraten „so viel entgegenzusetzen. Wir haben das Recht. Die Freiheit. Die Menschlichkeit. Das Wissen, wohin der Hass führt“, betonte Steinmeier.
Bundespräsident äußert sich indirekt zu möglichem AfD-Verbot
Ohne die AfD namentlich zu nennen, forderte der Bundespräsident: „Mit Extremisten darf es keine politische Zusammenarbeit geben – nicht in der Regierung, nicht in den Parlamenten.“ Ein Parteienverbot sei „die Ultima Ratio der wehrhaften Demokratie“. Ob die Voraussetzungen vorliegen, müsse geprüft und abgewogen werden. „Auf keinen Fall dürfen wir tatenlos sein, bis diese Fragen geklärt sind“, forderte Steinmeier.
Deutlich sprach er sich gegen die Argumentationslinie mancher Politiker aus, die ein solches Verfahren als „undemokratisch“ bezeichneten. „Sie haben es doch selbst in der Hand“, sagte Steinmeier. „Greifen sie unsere Verfassung an, stellen sie sich gegen sie, wollen sie ein anderes, nicht-freiheitliches System? Da ist die Antwort unserer Verfassung klar: Eine Partei, die den Weg in die aggressive Verfassungsfeindschaft beschreitet, muss immer mit der Möglichkeit des Verbots rechnen.“
Jetzt gehe es auch darum, dass sich die politische Mitte überzeugend von den „Demokratieverächtern und Extremisten“ abgrenze. Steinmeier zeigte sich überzeugt: Antidemokraten könnten nicht durch Beteiligung an der Macht beschwichtigt werden. Extremismus triumphiere, wenn ihn andere ermöglichten.
AfD spricht von Amtsmissbrauch
Die AfD kritisierte die Äußerungen Steinmeiers scharf. „Nie hat ein Bundespräsident sein Amt so missbraucht“, sagte der Erste Parlamentarische Geschäftsführer der AfD-Bundestagsfraktion, Bernd Baumann, dem „Handelsblatt“.
Steinmeier habe mit seiner Aussage „Wir müssen handeln“ zu einem Verbotsverfahren gegen die AfD aufgerufen. Zudem wolle Steinmeier in den Parlamenten jede Zusammenarbeit mit der in Umfragen stärksten politischen Kraft in Deutschland verhindern. Und er habe die AfD am Jahrestag des 9. November „in eine Reihe mit den Nazimördern“ gestellt.
„Möglich, dass wir nicht aus der Geschichte gelernt haben?“
Obwohl Deutschland ein starkes Land sei – mit gefestigter Demokratie, stabilem Rechtsstaat und leistungsfähiger Wirtschaft -, habe zugleich eine große Unruhe die Gesellschaft erfasst. „Immer häufiger höre ich besorgte Gespräche: ‚Wie wird es hier für uns weitergehen‘ – wenn extreme Parteien stärker werden, wenn Menschen mit Einwanderungsgeschichte, wenn Jüdinnen und Juden nicht mehr sicher sind? Ist es denn möglich, dass wir nicht aus der Geschichte gelernt haben?“, fragte Steinmeier.
Die Gesellschaft könne solchen Befürchtungen viel entgegensetzen. „Wir sind verschieden, leben auf dem Dorf oder in der Stadt, in Ost oder West, sind eingewandert oder hier geboren, aber gehören zusammen in dieses, in unser Land. Unser Patriotismus ist, ja, ein Patriotismus der leisen Töne. Er muss es sein, denn die Verantwortung für unsere Geschichte vergeht nicht.“
Aktive Demokratinnen und Demokraten
Auch wenn Steinmeier nach eigenen Worten nichts von Alarmismus und schrillen Untergangsszenarien hält, sei es an der Zeit, „dass wir den Gefahren illusionslos ins Auge sehen. Wir dürfen nicht gleichsam hineinrutschen erst in eine neue Faszination des Autoritären und dann in neue Unfreiheit, und hinterher sagen alle: ‚Das haben wir nicht gewollt. Das haben wir nicht gewusst.'“
Der Bundespräsident verwies darauf, dass es viele Menschen gebe, die schweigen und abwarten. „Ihnen möchte ich sagen: Mischen Sie sich ein! Was wir jetzt brauchen, sind aktive Demokratinnen und Demokraten, die den Mund aufmachen, im Parlament, beim Fußball, am Stammtisch, in der Schule, an der Bushaltestelle und am Arbeitsplatz.“
Was geschah bei den Novemberpogromen 1938?
In der Nacht vom 9. auf den 10. November 1938 sowie in den folgenden Tagen kam es im damaligen Deutschen Reich zu brutalen Angriffen auf Juden und jüdische Einrichtungen. Synagogen, Betstuben, jüdische Friedhöfe, Geschäfte und Versammlungsräume wurden zerstört, zahlreiche Menschen ermordet, Zehntausende in Konzentrationslager verschleppt.
Den Vorwand für die Ereignisse bildete das Attentat des 17-jährigen Herschel Grünspan auf den deutschen Diplomaten Ernst vom Rath in Paris am 7. November. Grünspan wollte mit seiner Tat gegen die Deportation von 17.000 Juden aus Deutschland an die polnische Grenze protestieren. Propagandaminister Joseph Goebbels nutzte den Anlass zu einer Hetzrede. Im ganzen Deutschen Reich organisierten SA- und NSDAP-Mitglieder daraufhin die Übergriffe gegen Juden.
Die Novemberpogrome markieren den Übergang von der Diskriminierung zur systematischen und gewaltsamen Verfolgung und Vernichtung der jüdischen Bevölkerung durch das NS-Regime.